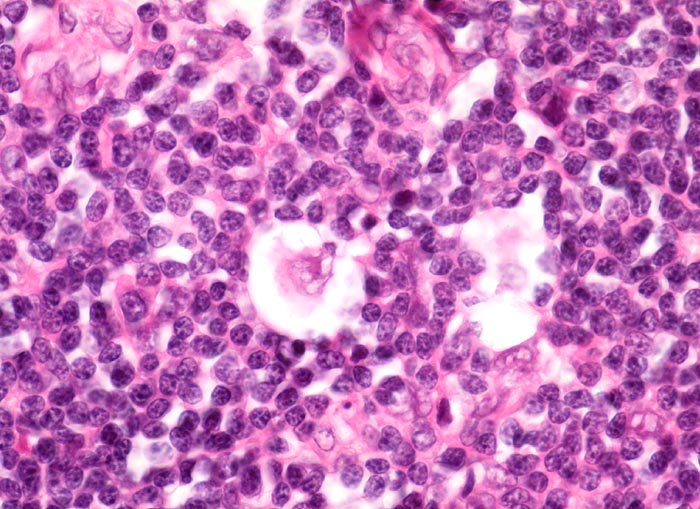

PathoPic – image database / PathoPic ID 3912 - Hodgkin-Lymphom, noduläre Sklerose: Lakunarzelle
de
Diagnose
Hodgkin-Lymphom, noduläre Sklerose: Lakunarzelle
Diagnose Gruppe
maligner Tumor
Topographie
Lymphknoten, mediastinal
Topographie Gruppe
Lymphatische Gewebe, KM, Milz
Beschreibung
Klinik
Mediastinaler Tumorbulk.
Kommentar
Im formalinfixierten Gewebe zeigen die neoplastischen Zellen bei der nodulären Sklerose eine Retraktion der Zytoplasmamembran. Dadurch scheint die Zelle in einer Lakune zu liegen. Deshalb werden die Tumorzellen auch Lakunarzellen genannt. Die Lakunarzellen können Aggregate bilden. Für sehr prominente Aggregate von Lakunarzellen wird der Begriff "syncytiale Variante" verwendet.
Bilder Typ
Histologie
Vergrösserung
630
Alter
21
Geschlecht
unbekannt
Datum
Ersteintrag: 28.09.2002